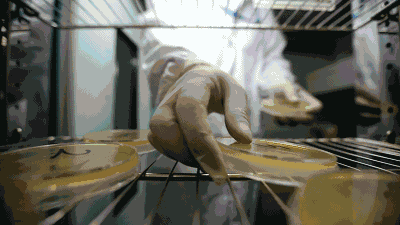
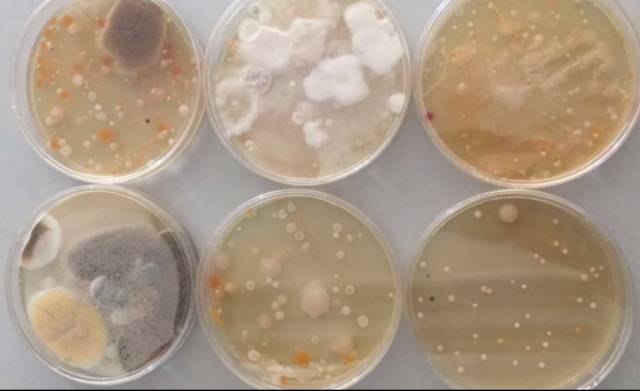

羞羞的问你一句:大家在上完厕所冲水的时候,马桶盖到底盖还是不盖呢?
有人说,不盖马桶盖,冲水的时候会把细菌给冲上来。那么卫生间的空气就会有细菌,刷牙、洗脸时都可能会被“二次污染”。
这到底是不是真的呢?今天的实验来告诉你答案。
实验开始
我们先往马桶里倒入干冰用来模拟马桶内的细菌
因为干冰的气体密度比空气大,所以,干冰产生的烟雾会沉在底部。
那么,当马桶内冲水的时候,水流和气流能够带动烟雾漂浮起来吗?
按下马桶开关的一瞬间,干冰烟雾瞬间往上飘散。
一直飘到了口腔和鼻腔附近,
像*史大**这种身高1米8的巨汉都会被喷到,
如果换作小孩子,显然更加躲不过了。
专家指出:
烟雾飘散的高低程度主要是由气流的大小决定。
水在流动当中肯定会产生气流,那么冲得越急,水流越快气流就越大 、它飘得就越高 。干冰雾气的分子比细菌个头大一些,上扬会更高,漂浮时间也会更长。
我们随机提取了一家卫生间的空气样本,
然后送往专业微生物实验室进行培养、检测。
48小时之后,结果出来了,
通过培养皿培养出来的结果我们来观察。
空气样本中含有以下细菌:
主要是藤黄微球菌,枯草芽孢杆菌,大肠埃细菌,像黑曲霉、白色念珠菌、红酵母菌、毛霉、黄曲霉等。
结果出乎意料,有的培养皿检验出来的菌落总数,多到不可计数。
那么,这些细菌和真菌,对人体有害吗?
专家指出:
细菌能否致病主要有几个因素:
1 细菌毒性
2 细菌的数量
3 是人体自身的免疫力
这些细菌都是在环境当中存在的。
比如说个人本来就是抵抗力很低、免疫功能很差的,吸进去有可能就会致病 。
我们在临床上看到的黄曲霉它会引起肺炎 ,它所产生的黄曲霉毒素,会引起一些中毒性的疾病 。
这些细菌除了能引发一些支气管炎、肺炎、哮喘等呼吸道感染疾病,
卫生间的微生物还会影响皮肤的健康。
特别是小孩子,它会引起一些细菌性的皮肤病,比如脓疱、疮毛囊炎等等 。
而真菌 ,比如说股癣体癣特别是女性还有阴道炎等等 霉菌性阴道炎都有可能通过这个途径传染。
家里卫生间环境相对温暖湿润,菌类会大量繁殖,尤其是小孩子抵抗力差,需要提前预防。
所以,冲马桶时需要盖马桶盖,防止排泄物的细菌外溢。
可是,要养成盖马桶盖这个习惯,相信对很多男士是很难做到。
而且即使守住马桶这一关,卫生间还是个容易滋生细菌的地方。
那我们平时使用的排气扇和开窗通风等方法有没有效果呢?
首先测试一下开窗通风法。
此时,硫化氢浓度已经爆表,超出了100ppm。
如果换成细菌的话,室内空气就会被整体污染。
通风20分钟,卫生间的湿度也仅仅下降到64%。
这距离人体最适宜50%—60%的标准,还差了很多,除湿效果很差。
如果换成排气扇,效果又会怎么样呢?
我们把卫生间的环境恢复到初始状态。
排气扇打开20分钟后,吸力还是很强劲的。
现在室内的硫化氢含量下降了很多,基本上闻不到臭味了,效果还是蛮明显的

此时,测量的结果为硫化氢浓度为0;但湿度还有67%。
总体来看,排气扇和开窗通风效果相似,对改善卫生间的空气质量不算明显总
1卫生间确实是一个藏污纳垢的地方,细菌急剧。在免疫力下降的情况下,会有致病的可能。
2传统的开窗通风法、或者换气干燥,起不到杀菌作用,顶多就是抑制细菌生长,但缺点很明显:耗时太长,效果不明显。
3如果想改善卫生间环境,借助一些杀菌装置,能够在沐浴后自动进行快速除湿,引进新鲜空气,起到净化效果。